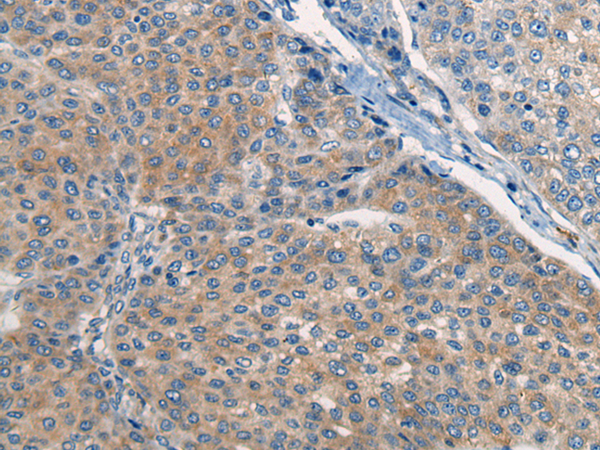

-
分类: 科研抗体货号: P13120别名: HPT1; CDH16; HPT-1应用: IHC反应种属: Human
-
分类: 科研抗体货号: P13104别名: COBRA1; NELF-B应用: IHC反应种属: Human, Mouse
-
分类: 科研抗体货号: P13140别名: SMAP; p120; SMAP2应用: IHC反应种属: Human
-
分类: 科研抗体货号: P13103别名: COPD应用: IHC反应种属: Human, Mouse, Rat
-
分类: 科研抗体货号: P13119别名: ZRF1; ZUO1; MPP11; MPHOSPH11应用: IHC反应种属: Human, Mouse, Rat
-
分类: 科研抗体货号: P13139别名: APOB48R; APOB100R应用: IHC反应种属: Human
-
分类: 科研抗体货号: P13102别名: NB-2; HNB-2s应用: IHC反应种属: Human, Mouse, Rat
-
分类: 科研抗体货号: P13118别名: MEK; MKK7; JNKK2; MEK 7; MAPKK7; PRKMK7; SAPKK4; SAPKK-4应用: IHC反应种属: Human, Mouse, Rat
-
分类: 科研抗体货号: P13138别名: ASAH3; ALKCDase1应用: IHC反应种属: Human
-
分类: 科研抗体货号: P13117别名: ODF; OPGL; sOdf; CD254; OPTB2; RANKL; TNLG6B; TRANCE; hRANKL2应用: WB,IHC反应种属: Human, Mouse, Rat

鄂公网安备42018502007531号
鄂公网安备42018502007531号

